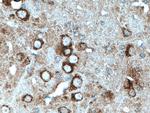
TRPA1 Antibody in Immunohistochemistry (Paraffin) (IHC (P))

Search
Proteintech
TRPA1 Polyclonal Antibody
{{$productOrderCtrl.translations['antibody.pdp.commerceCard.promotion.promotions']}}
{{$productOrderCtrl.translations['antibody.pdp.commerceCard.promotion.viewpromo']}}
{{$productOrderCtrl.translations['antibody.pdp.commerceCard.promotion.promocode']}}: {{promo.promoCode}} {{promo.promoTitle}} {{promo.promoDescription}}. {{$productOrderCtrl.translations['antibody.pdp.commerceCard.promotion.learnmore']}}
产品信息
19124-1-AP
种属反应
宿主/亚型
分类
类型
抗原
偶联物
形式
浓度
规格
纯化类型
保存液
内含物
保存条件
运输条件
靶标信息
TRPA1 is a TRP-related channel that responds to cold temperatures and pungent compounds and plays a role in both nociceptor and hair cell transduction. TRPA1 is a transformation -associated gene product in lung epithelia, whereas its protein distribution is primarily restricted to sensory neurons. Blocking TRPA1 may be a therapeutic target for treating cold hyperalgesia caused by inflammation and nerve damage. It is now known that TRPA1 protein is also widely expressed outside of the CNS and is dys-regulated during oncogenic transformation. The structure of TRPA1 is highly related to both the protein ankyrin and transmembrane proteins. The specific function of TRPA1 has not yet been determined; however, studies indicate the function may involve a role in signal transduction and growth control.
仅用于科研。不用于诊断过程。未经明确授权不得转售。
生物信息学
蛋白别名: ANKTM1; ankyrin-like with transmembrane domains 1; Ankyrin-like with transmembrane domains protein 1; nompC; p120; Transformation-sensitive protein p120; Transient receptor potential cation channel subfamily A member 1; TRPA-1; Wasabi receptor
基因别名: ANKTM1; FEPS; FEPS1; p120; TRPA1; TRPA1b
UniProt ID: (Human) O75762, (Mouse) Q8BLA8
Entrez Gene ID: (Human) 8989, (Mouse) 277328